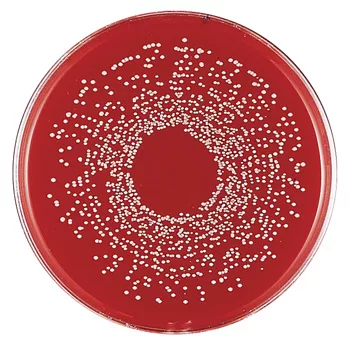

Advances in Spiral Plating Increase Reproducibility and Cost Savings
The number of food samples that require bacterial analysis continues to increase each year. The importance of food safety to the public is greater than ever. The United States Department of Agriculture estimates 75 million cases of foodborne illnesses per year, which increases the need for rapid results in bacterial testing. Industry has done a tremendous job developing new instrumentation and tests to fill this need. However, food researchers and scientists must still validate their work compared to primary, traditional, microbiological methods.
Drs. Jim Gilchrist and Jeptha Campbell conceived the spiral plating method at the U.S. Food and Drug Administration in the early 1970s. The technique was originally developed to plate and enumerate organisms in milk, but has since been utilized in a wide variety of industries and on a broad range of product types. In the spiral plating method, a stylus deposits precise syringe-controlled amounts of sample onto a rotating agar plate in an outward motion. Due to this unique plating action, an Archimedes spiral pattern is created that exponentially reduces the number of microbes placed along the spiral track. This exponential reduction gives the same effect as a series of up to four 10-fold dilutions on one plate without actually adding any diluent.
The Autoplate® Spiral Plating System
Advanced Instruments, Inc. (formerly Spiral Biotech, Inc.) based in Norwood, MA, has facilitated vast improvements in the field of spiral plating. The Autoplate is the latest in microprocessor-controlled spiral plating technology and uses an AOAC-approved method (#977.27) to directly plate microbial suspensions with concentrations from 40 to 1,000,000 colony-forming units (CFU)/ml on 10-cm plates without the need for serial dilutions. This automated method’s unique features result in greater sample repeatability and significant savings in time, labor and disposable materials over conventional plating methods.
Candidates for the Autoplate
Due to the high count of bacteria in many samples, determining their concentration typically requires a series of dilutions of the sample to assure that individual colonies can be distinguished. The conventional manual method of performing these serial dilutions, while effective, is clearly labor and material intensive. Additionally, growing demands on the microbiology laboratory require a difficult task: producing high-quality results quickly and repeatedly. This is particularly troublesome for high-volume laboratories. Many microbiology labs have to make a decision: Do we sacrifice quality for speed?
This system helps the microbiologist save time and money while also repeatedly delivering plates of the highest quality. It also allows a substantial reduction in operating costs by eliminating up to 75% of materials required with serial dilutions and providing a 4-log dilution effect across a standard plate. This combination of quality results and an efficient system make the Autoplate a dominant player in the marketplace.
This system was designed to help laboratory technicians utilize their time and materials more effectively. The ideal customer plates samples regularly (>25 per week), uses a sample with a microbial concentration greater than 1,000 CFU/g or CFU/ml and has samples available in volumes greater than 200 ml. Any application where counts are high, dilutions need to be made and standardization and reproducibility are important is an opportunity for spiral plating.
Application
In the food industry, there is continual research to determine the prevalence of pathogens, improve detection rates and develop methods to raise the quality of the food supply in both raw and processed food items and their ingredients. Microbes in raw milk and other dairy products such as cheese, buttermilk and yogurt, including Lactobacillus, which are useful in the production process, must be enumerated. Total viable organism counts on standard methods (e.g., plate count) or tryptic soy agars are often required. The Autoplate makes plating such items easier. It is also ideal for those interested in utilizing selective or differential agars since it can make up to 10 different plates using only one aspiration of sample.
Conclusion
Spiral plating is an ideal tool for both research and quality assurance personnel. Using this system allows the processing of large numbers of samples rapidly with consistently reliable results. Fully automated technologies, such as PCR, are terrific for rapid testing in the laboratory, but many people are still required to plate their samples in accordance with traditional methods. Spiral plating will help these people.
Spiral plating saves time, labor and supplies, which means cost savings. The plates made with the Autoplate Spiral Plating System are clean, repeatable and accurate. All of these benefits lead to the two most important qualities in a spiral plating system: efficiency and quality. This method is the only automated plating system that combines ease-of-use, precision and speed to provide microbiologists all the traditional benefits of spiral plating and more.
www.aicompanies.com
Looking for quick answers on food safety topics?
Try Ask FSM, our new smart AI search tool.
Ask FSM →







